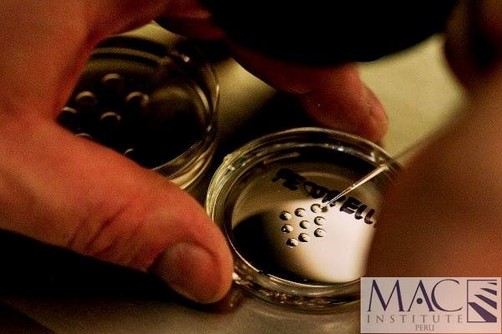

Mac Institute Peru te da la oportunidad de ampliar tus conocimientos sobre este campo.MEDICINA REGENERATIVA ANTI-AGINGADMINISTRACION Y CLINICADIPLOMADO INTERNACIONALDURACION DEL PROGRAMA: 80 HORASLUGAR: NEW JERSEY - NEW YORKOBJETIVO: Capacitación científica en la aplicación de conocimientos, técnicas y terapias. Para desarrollar habilidades en la terapia medica regenerativa incluyendo las terapias con células madre entre los médicos asistentes.PERFIL OCUPACIONAL: Médicos, Cirujanos y especialistas.JUSTIFICACION Debido a la gran cantidad de enfermedades devastadoras sin notorias mejorías que seregistran a diario en los servicios de salud, se creara por medio de la educacióncontinuada una red medica especial que tendrá como fin atender al paciente crónicoafectado con este tipo de enfermedades, desde el enfoque integral de la medicina,incluyendo la terapia con células madre reconocida a nivel mundial por su excelenciaen los resultados de tratamientos, aportando bienestar y salud a la comunidad.OBJETIVO GENERALDesarrollar habilidades en la terapia médica regenerativa incluyendo las terapias concélulas madre entre los médicos asistentes para que luego sean aplicadas en el áreaque se desempeña el médico o en medicina antienvejecimiento.OBJETIVOS ESPECIFICOS1. Permitirle a los asistentes capacidades para valorar, diagnosticar y realizar tratamientos relacionados con la medicina regenerativa inclusive las y terapias con Células Madre.2. Profundizar en los conocimientos sobre las diferentes técnicas científicas de las medicinas occidentales y orientales inclusive terapias con las Células madre.3. Comprender el uso y aplicación de las terapéuticas en la medicina antienvejecimiento con las técnicas propuestas en el diplomado en medicina regenerativa y terapias con células madre.4. Realizar prácticas clínicas con las diversas técnicas estudiadas.ACTIVIDADES Y PRACTICAS MEDICAS1 . PROGRAMA MEDICO DESARROLLO DE CONTENIDOS MEDICOS EN NEW YORK Y NEW JERSEY2. PROGRAMA DE FORMACION EMPRESARIAL NEUROECONOMIA EMPRESARIAL - NEW JERSEY -3. PROGRAMA DE FACILITAMIENTO TECNOLOGIAS INFORMATICAS PARA LA EMPRESA MEDICA – NEW JERSEY -4. PROGRAMA COMPLEMENTARIO TOUR TURISTICO Y CULTURAL NEW YORK – NEW JERSEY –PROGRAMA MEDICOMODULO I Conceptos de Inmunología y Hematología•Fisiología •Bases fundamentales •Inmunología del Envejecimiento•Hematología del Envejecimiento•Conceptos de nuevas terapias regenerativasMODULO IIManejo de enfermedades en la vejez con Medicina Regenerativa•Biología de la regeneración antienvejecimiento.•Manejos y protocolos de enfermedades:• Cardiopulmonares• Neurológicas• Endocrinas •Prácticas con pacientes MODULO IIIManejos y protocolos de medicina regenerativa en enfermedades •Osteoarticulares •Circulatorias•Gástricas•Practicas con pacientes MODULO IV Manejos y protocolos de medicina regenerativa en enfermedades •Sobrepeso•Obesidad •Mal nutrición •Practica con pacientesMODULO V•Manejo y protocolos enfermedades Autoinmunes con medicina regenerativa•Conceptos•Algunos Protocolos•Manejo terapéutico•Practica con pacientesMODULO VICélulas madre en medicina estética antienvejecimiento •Técnicas de aplicación células autólogas•Protocolos de células liofilizadas•Practica con pacientesNEUROECONOMIA EMPRESARIAL1. EL EMPRENDIMIENTO BIOSOCIAL2. BASES FISICAS DEL CONECTOMA EMPRENDEDOR3. ACTIVACION DEL EMPRENDIMIENTO EMPRESARIAL DESDE NEUROCIENCIAS4. FISIOLOGIA Y QUIMICA DEL EMPRENDIMIENTO 5. LA EMPRESA DE SERVICIOS MEDICOS INTELIGENTETECNOLOGIA INFORMATICA PARA EL SERVICIO MEDICO O CLINICO1. LAS CONEXIONES ENTRE OFERTA Y DEMANDA EN LOS SERVICIOS MEDICOS DEL SIGLO 21 MEDIANTE DISPOSITIVOS INTELIGENTES2. APLICACIONES DEL POS (HERRAMIENTA TECNOLOGICA QUE INCLUYE SOFTWARE ESPECIALIZADO) EN CONSULTORIOS O CLINICAS3. LOS DISPOSITIVOS Y LAS MAQUINAS APROPIADASPara mayor detalles e informes escribir a macinstituteperu@gmail.com / macinstituteperu@aol.com , ò pueden llamar al 717-2947 / 988180418RPM # 730278 / #943485107 / 998223596